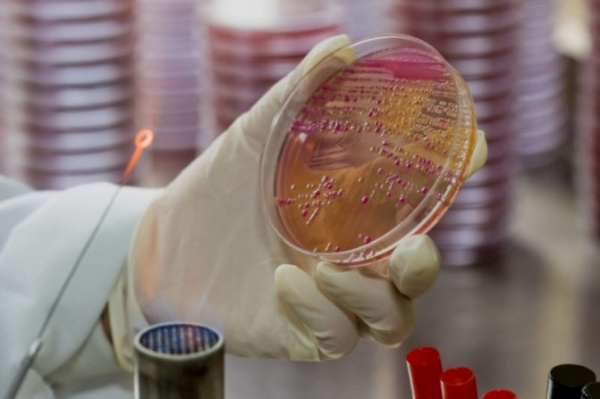
Бакпосев мочи на питательные среды

Бактериурия. Классификация бактерурий.
Добавил пользователь Morpheus Обновлено: 07.01.2026
Моча – продукт обмена веществ, образующийся в почках в результате фильтрации жидкой части крови, а также процессов реабсорбции и секреции разных аналитов. Состоит на 96% из воды, остальные 4% приходятся на растворенные в ней азотистые продукты обмена белков (мочевина, мочевая кислота, креатинин и др.), минеральные соли и др. вещества.
Общий анализ мочи у детей и взрослых включает оценку физико-химических характеристик мочи и микроскопию осадка. Данное исследование позволяет оценить функцию почек и других внутренних органов, а также выявить воспалительный процесс в мочевых путях
Физико-химические исследования мочи включают оценку следующих показателей:
- цвет;
- прозрачность мочи;
- удельный вес (относительная плотность);
- рН;
- концентрация белка;
- концентрация глюкозы;
- концентрация билирубина;
- концентрация уробилиногена;
- концентрация кетоновых тел;
- концентрация нитритов;
- концентрация гемоглобина.
Микроскопия мочевого осадка включает оценку следующих объектов:
- Организованный осадок мочи:
- присутствие эритроцитов;
- лейкоцитов;
- эпителиальных клеток;
- цилиндров;
- бактерии;
- дрожжевых грибов;
- паразиты;
- опухолевые клетки;
Физико-химические свойства
Оценка физических свойств мочи, таких как запах, цвет, мутность, проводится органолептическим методом. Удельный вес мочи измеряется при помощи урометра, рефрактометра или оценивается методами «сухой химии» (тест-полоски) – визуально или на автоматических анализаторах мочи.
У взрослого человека моча желтого цвета. Оттенок ее может колебаться от светлого (почти бесцветного) до янтарного. Насыщенность желтого цвета мочи зависит от концентрации растворенных в ней веществ. При полиурии моча имеет более светлую окраску, при уменьшении диуреза приобретает насыщенно-желтый оттенок. Окраска меняется при приеме лекарственных препаратов (салицилаты и др.) или употреблении некоторых пищевых продуктов (свекла, черника).
Патологически измененная окраска мочи бывает при:
- гематурии – вид «мясных помоев»;
- билирубинемии (цвет пива);
- гемоглобинурии или миоглобинурии (черный цвет);
- лейкоцитурии (молочно-белый цвет).
Прозрачность мочи
В норме свежесобранная моча совершенно прозрачна. Мутность мочи обусловлена наличием в ней большого количества клеточных образований, солей, слизи, бактерий, жира.
В норме запах мочи нерезкий. При разложении мочи бактериями на воздухе или внутри мочевого пузыря, например в случае цистита, появляется аммиачный запах. В результате гниения мочи, содержащей белок, кровь или гной, например при раке мочевого пузыря, моча приобретает запах тухлого мяса. При наличии в моче кетоновых тел моча имеет фруктовый запах, напоминающий запах гниющих яблок.
Реакция мочи
Почки выделяют из организма «ненужные» и задерживают необходимые вещества для обеспечения обмена воды, электролитов, глюкозы, аминокислот и поддержания кислотно-основного баланса. Реакция мочи – рН – в значительной мере определяет эффективность и особенность этих механизмов. В норме реакция мочи слабокислая (рН 5,0–7,0). Она зависит от многих факторов: возраста, диеты, температуры тела, физической нагрузки, состояния почек и др. Наиболее низкие значения рН – утром натощак, наиболее высокие – после еды. При употреблении преимущественно мясной пищи – реакция более кислая, при употреблении растительной – щелочная. При длительном стоянии моча разлагается, выделяется аммиак и рН сдвигается в щелочную сторону.
Щелочная реакция мочи характерна для хронической инфекции мочевыводящих путей, также отмечается при поносе и рвоте.
Кислотность мочи увеличивается при лихорадочных состояниях, сахарном диабете, туберкулезе почек или мочевого пузыря, почечной недостаточности.
Удельный вес (относительная плотность) мочи
Относительная плотность отражает функциональную способность почек концентрировать и разводить мочу. Для нормально функционирующих почек характерны широкие колебания удельного веса мочи в течение суток, что связано с периодическим приемом пищи, воды и потерей жидкости организмом. Почки в различных условиях могут выделять мочу с относительной плотностью от 1,001 до 1,040 г/мл.
- гипостенурию (колебания удельного веса мочи менее 1,010 г/мл);
- изостенурию (появление монотонного характера удельного веса мочи соответствующее таковому первичной мочи (1,010 г/мл);
- гиперстенурию (высокие значения удельного веса).
Максимальная верхняя граница удельного веса мочи у здоровых людей – 1,028 г/мл, у детей – 1,025 г/мл. Минимальная нижняя граница удельного веса мочи составляет 1,003–1,004 г/мл.
Для оценки химического состава мочи в настоящее время, как правило, применяют диагностические тест-полоски (метод «сухой химии»), выпускаемые разными производителями. Химические методы, используемые в тест-полосках, основаны на цветных реакциях, дающих изменение цвета тестовой зоны полоски при разных концентрациях аналита. Изменение окраски определяется визуально или с помощью отражательной фотометрии с использованием полуавтоматических или полностью автоматизированных анализаторов мочи, результаты оцениваются качественно или полуколичественно. При обнаружении патологического результата исследование может быть выполнено повторно с использованием химических методов.
Белок в норме в моче отсутствует или присутствует в неопределяемой обычными методами концентрации (следы). Выявляют несколько видов протеинурии (появление белка в моче):
- физиологическая (ортостатическая, после повышенной физической нагрузки, переохлаждении);
- клубочковая (гломерулонефрит, действие инфекционных и аллергических факторов, гипертоническая болезнь, декомпенсация сердечной деятельности);
- канальцевая (амилоидоз, острый канальцевый некроз, интерстициальный нефрит, синдром Фанкони).
- преренальная (миеломная болезнь, некроз мышечной ткани, гемолиз эритроцитов);.
- постренальная (при циститах, уретритах, кольпитах).
В норме глюкоза в моче отсутствует. Появление глюкозы в моче может иметь несколько причин:
- физиологическая (стресс, прием повышенного количества углеводов);
- внепочечная (сахарный диабет, панкреатит, диффузные поражения печени, рак поджелудочной железы, гипертиреоз, болезнь Иценко-Кушинга, черепно-мозговые травмы, инсульты);
- ренальная (почечный диабет, хронические нефриты, острая почечная недостаточность, беременность, отравление фосфором, некоторыми лекарственными препаратами).
Билирубин в норме в моче отсутствует. Билирубинурия выявляется при паренхиматозных поражениях печени (гепатиты), механической желтухе, циррозах, холестазе, в результате действия токсических веществ.
Уробилинген
Нормальная моча содержит низкую концентрацию (следы) уробилиногена. Уровень его резко возрастает при гемолитической желтухе, а также при токсических и воспалительных поражениях печени, кишечных заболеваниях (энтериты, запоры).
Кетоновые тела
К кетоновым телам относятся ацетон, ацетоуксусная и бета-оксимаслянная кислоты. Увеличение выделения кетонов с мочой (кетонурия) появляется при нарушении углеводного, липидного или белкового обмена.
Нитриты в нормальной моче отсутствуют. В моче они образуются из нитратов пищевого происхождения под влиянием бактерий, если моча не менее 4 часов находилась в мочевом пузыре. Обнаружение нитритов в правильно хранившихся образцах мочи свидетельствует об инфицировании мочевого тракта.
В норме в моче отсутствует. Гемоглобинурия – результат внутрисосудистого гемолиза эритроцитов с выходом гемоглобина – характеризуется выделением мочи красного или темно-бурого цвета, дизурией, нередко болями в пояснице. При гемоглобинурии эритроциты в осадке мочи отсутствуют.
Микроскопия осадка мочи
Осадок мочи делят на организованный (элементы органического происхождения – эритроциты, лейкоциты, эпителиальные клетки, цилиндры и др.) и неорганизованный (кристалы и аморфные соли).
Методы исследования
Исследование проводят визуально в нативном препарате с использованием микроскопа. Кроме визуального микроскопического исследования, применяется исследование с помощью автоматических и полуавтоматических анализаторов.
За сутки с мочой выделяется 2 млн. эритроцитов, что при исследовании осадка мочи составляет в норме 0–3 эритроцита в поле зрения для женщин и 0–1 эритроцит в поле зрения у мужчин. Гематурией называют увеличение эритроцитов в моче выше указанных значений. Выделяют макрогематурию (изменен цвет мочи) и микрогематурию (цвет мочи не изменен, эритроциты обнаруживаются только при микроскопии).
В мочевом осадке эритроциты могут быть неизмененные (содержащие гемоглобин) и измененные (лишенные гемоглобина, выщелоченные). Свежие, неизмененные эритроциты характерны для поражения мочевыводящих путей (цистит, уретрит, прохождение камня).
Появление в моче выщелоченных эритроцитов имеет большое диагностическое значение, т.к. они чаще всего имеют почечное происхождение и встречаются при гломерулонефритах, туберкулезе и других заболеваниях почек. Для определения источника гематурии применяют трехстаканную пробу. При кровотечении из уретры гематурия бывает наибольшей в первой порции (неизмененные эритроциты), из мочевого пузыря – в последней порции (неизмененные эритроциты). При других источниках кровотечения эритроциты распределяются равномерно во всех трех порциях (выщелоченные эритроциты).
Лейкоциты в моче здорового человека содержатся в небольшом количестве. Норма для мужчин 0–3, для женщин и детей 0–6 лейкоцитов в поле зрения.
Увеличения числа лейкоцитов в моче (лейкоцитурия, пиурия) в сочетании с бактериурией и наличием клинических симптомов свидетельствует о воспалении инфекционной природы в почках или мочевыводящих путях.
Эпителиальные клетки
В мочевом осадке практически всегда встречаются клетки эпителия. В норме в анализе мочи не больше 10 эпителиальных клеток в поле зрения.
Эпителиальные клетки имеют различное происхождение:
- клетки плоского эпителия попадают в мочу из влагалища, уретры, их наличие особого диагностического значения не имеет;
- клетки переходного эпителия выстилают слизистую оболочку мочевого пузыря, мочеточников, лоханок, крупных протоков предстательной железы. Появление в моче большого количества клеток такого эпителия может наблюдаться при мочекаменной болезни, новообразованиях мочевыводящих путей и воспалении мочевого пузыря, мочеточников, лоханок, крупных протоков предстательной железы;
- клетки почечного эпителия выявляются при поражении паренхимы почек, интоксикациях, лихорадочных, инфекционных заболеваниях, расстройствах кровообращения.
Цилиндр – белок, свернувшийся в просвете почечных канальцев и включающий в состав своего матрикса любое содержимое просвета канальцев. Цилиндры принимают форму самих канальцев (слепок цилиндрической формы). В норме в пробе мочи, взятой для общего анализа цилиндры отсутствуют. Появление цилиндров (цилиндрурия) является симптомом поражения почек.
Различают цилиндры:
- гиалиновые (с наложением эритроцитов, лейкоцитов, клеток почечного эпителия, аморфных зернистых масс);
- зернистые;
- восковидные;
- пигментные;
- эпителиальные;
- эритроцитарные;
- лейкоцитарные;
- жировые.
Неорганизованный осадок
Основным компонентом неорганизованного осадка мочи являются соли в виде кристаллов или аморфных масс. Характер солей зависит от рН мочи и других свойств мочи. Например, при кислой реакции мочи обнаруживаются мочевая кислота, ураты, оксалаты, при щелочной реакции мочи – кальций, фосфаты, мочекислый аммоний. Особого диагностического значения неорганизованный осадок не имеет, косвенно можно судить о склонности пациента к мочекаменной болезни. При ряде патологических состояний в моче могут появляться кристаллы аминокислот, жирных кислот, холестерина, билирубина, гематоидина, гемосидерина и т.д.
Появление в моче лейцина и тирозина говорит о выраженном расстройстве обмена веществ, отравлении фосфором, деструктивном заболевании печени, пернициозной анемии, лейкозе.
Цистин – врожденное нарушение цистинового обмена – цистиноз, цирроз печени, вирусный гепатит, состояние печеночной комы, болезнь Вильсона (врожденный дефект обмена меди).
Ксантин – ксантинурия обусловлена отсутствием ксантиноксидазы.
В норме моча в мочевом пузыре стерильна. При мочеиспускании в нее попадают микробы из нижнего отдела уретры.
Появление в общем анализе мочи бактерий и лейкоцитов на фоне симптомов (дизурия или лихорадка) свидетельствует о клинически проявляющейся мочевой инфекции.
Наличие в моче бактерий (даже в сочетании с лейкоцитами) при отсутствии жалоб расценивается как бессимптомная бактериурия. Бессимптомная бактериурия повышает риск инфекции мочевых путей, особенно при беременности.
Дрожжевые грибы
Обнаружение грибов рода Саndida свидетельствует о кандидамикозе, возникающего чаще всего в результате нерациональной антибиотикотерапии, приеме иммуносупрессоров, цитостатиков.
В осадке мочи могут быть обнаружены яйца кровяной шистосомы (Schistosoma hematobium), элементы эхинококкового пузыря (крючья, сколексы, выводковые капсулы, обрывки оболочки пузыря), мигрирующие личинки кишечной угрицы (стронгилиды), смываемые мочой с промежности онкосферы тениид, яйца острицы (Enterobius vermiсularis) и патогенные простейшие – трихомонады (Trichomonas urogenitalis), амебы (Entamoeba histolitika – вегетативные формы).
Условия взятия и хранения образца
Для общего анализа собирают утреннюю порцию мочи. Сбор мочи проводят после тщательного туалета наружных половых органов без применения антисептиков. Для исследования используется свежесобранная моча, хранившаяся до анализа не более четырех часов. Образцы стабильны при температуре 2–8 °С не более 2 сут. Использование консервантов нежелательно. Перед исследованием мочу тщательно перемешивают.
Бессимптомная бактериурия
Бессимптомная бактериурия – рост бактерий при бактериологическом анализе мочи у лиц, у которых отсутствуют симптомы инфекции мочевой системы. Это явление свидетельствует о колонизации (заселении) мочевых путей бактериями коменсалами, то есть такими, которые не предоставляют организму-носителю ни вреда, ни пользы. Вместе с этим, результаты клинических исследований свидетельствуют, что бессимптомная бактериурия может защищать от развития симптоматической инфекции мочевой системы, которая вызывается патогенными микроорганизмами, то есть теми, которые вызывают заболевания. Итак, бессимптомную бактериурию можно рассматривать, как симбиоз человека и микроорганизма, а ее лечение должно проводиться только в тех случаях, когда его польза доказана.
Бессимптомная бактериурия является достаточно распространенным явлением и наблюдается у 1-5% здоровых женщин до менопаузы. Частота бессимптомной бактериурии увеличивается у пожилых лиц (мужчин и женщин) до 4-19%. Бессимптомная бактериурия наблюдается у 0,7%-27% больных сахарным, у 2-10% беременных и 23-89% пациентов с повреждением спинного мозга. Бессимптомная бактериурия редко наблюдается у молодых мужчин и всегда требует проведения дифференциальной диагностики с хроническим бактериальным простатитом.
Диагностика
Диагностическим критерием бессимптомной бактериурии является положительный результат бактериологического исследования средней порции мочи (то есть микробное число 10 5 КОЕ/мл, КОЕ – колониеобразующая единица) в двух пробах у женщин (взятых с интервалом не менее 24 часов) и в одной пробе у мужчин, у которых отсутствуют клинические симптомы инфекции мочевой системы. Необходимо заметить, что изменения в общем анализе мочи в виде лейкоцитурии не относящиеся к клинических симптомов инфекции мочевых путей.
У лиц с катетеризованим мочевым пузырем микробное число, что является достаточным для установления диагноза бессимптомной бактериурии составляет 10 2 КОЕ/мл (как для женщин, так и для мужчин).
В случае выявления бессимптомной бактериурии обязательным является определение остаточного объема мочи в мочевом пузыре, а цистоскопия должна назначаться по дополнительным показаниям. У мужчин обязательно исключают наличие хронического бактериального простатита. При наличии колонизации микроорганизмов, продуцирующих уреазу, например Proteus mirabilis, обязательно проводят диагностику мочекаменной болезни.
Лечение
У лиц с отсутствующими факторами риска развития инфекции мочевых путей бессимптомная бактериурия не приводит к заболеванию почек либо к их повреждению. Более того, рандомизированные контролируемые исследования детей и женщин показали, что лечение бессимптомной бактериурии увеличивает вероятность развития симптоматической инфекции мочевых путей, по сравнению с теми, кому бессимптомную бактериурию не лечили. Следовательно, проведение скрининга (рутинной диагностики заболевания у пациентов, которые не имеют его симптомов) и лечение бессимптомной бактериурии у пациентов (женщин и юношей) с отсутствующими факторами риска развития инфекции мочевых путей не рекомендовано (уровень доказательности 1b, качество доказательств А).
У пациентов с рецидивирующими симптоматическими инфекциями мочевых путей без факторов риска был продемонстрирован протекторный эффект спонтанной бессимптомной бактериурии. Итак, лечение бессимптомной бактериурии у пациенток с рецидивирующим течением симптоматической инфекции мочевых путей не рекомендовано (уровень доказательности 1b, качество доказательств А). Отличной является ситуация, когда при бессимптомной бактериурии оказывается и сама бактерия, которая была причиной развития симптоматической инфекции мочевых путей у данного пациента. В таком случае, необходимо рассмотреть возможность лечения бессимптомной бактериурии для эрадикации (удаления) микроорганизма (уровень доказательности 4, качество доказательств С).
У беременных бессимптомная бактериурия является достаточно распространенной и связана с повышенным риском развития симптоматической инфекции мочевых путей, в т.ч. пиелонефрита. Вместе с этим, доказательства связи между бессимптомной бактериурией и преждевременными родами (невынашиванием) слабые. Согласно большинству рекомендаций необходимо проводить скрининг и лечение бессимптомной бактериурии у беременных, что может представлять значительную проблему из-за нежелательных эффектов антибактериальной терапии на плод. При этом, доказательства положительных последствий лечения бессимптомной бактериурии у беременных являются слабыми и не свидетельствуют о его пользе. Последние европейские рекомендации не дают общих рекомендации в такой ситуации и советуют действовать в соответствии с национальным медико-технологических документов. На сегодня в Украине отсутствуют стандарты или протоколы утвержденные МЗ Украины, посвященные проблеме бессимптомной бактериурии. Следовательно, решение о тактике лечения беременной с бессимптомной бактериурией остается на усмотрение врачей.
Предварительный осмотр врачом, при необходимости собирается команда, в которую может войти врач, который направил пациента
Бактериурия
Бактериурия - наличие бактерий в моче. Бактериурия, сопровождающаяся симптомами, представляет собой инфекцию мочевыводящих путей, тогда как бактериурия без симптомов известна как бессимптомная бактериурия. Диагноз ставится на основании анализа мочи или посева мочи. Escherichia coli - наиболее часто встречающаяся бактерия. Людей без симптомов обычно не следует проверять на наличие этого заболевания. Дифференциальный диагноз включает заражение.
Если симптомы присутствуют, лечение обычно проводится антибиотиками. Бактериурия без симптомов обычно не требует лечения. Исключения могут быть беременными, недавно перенесшими трансплантацию почки, маленькими детьми со значительным пузырно-мочеточниковым рефлюксом, а также тех, кто перенес операцию на мочевыводящей тракт.
Бактериурия без симптомов присутствует примерно у 3% здоровых женщин среднего возраста. В домах престарелых этот показатель достигает 50% среди женщин и 40% среди мужчин. У тех, у кого длительное время постоянный мочевой катетер, частота составляет 100%. До 10% женщин заболевают инфекциями мочевыводящих путей в течение определенного года, и половина всех женщин в какой-то момент жизни страдает хотя бы одной инфекцией.
Содержание
- 1 Признаки и симптомы
- 1.1 Бессимптомное течение
- 1.2 Симптоматический
- 2.1 Скрининг
- 3.1 Бессимптомное
- 3.2 Симптоматическое
Признаки и симптомы
Бессимптомная
Бессимптомная бактериурия - это бактериурия без сопутствующих симптомов инфекции мочевыводящих путей. Это чаще встречается у женщин, пожилых людей, пациентов учреждений длительного ухода, а также у людей с диабетом, катетерами мочевого пузыря и травмами спинного мозга. У людей с длительным сроком действия катетера Фолея всегда наблюдается бактериурия. Хроническая бессимптомная бактериурия встречается у 50% населения, получающего долгосрочное лечение.
Существует связь между бессимптомной бактериурией у беременных с низкой массой тела при рождении, преждевременными родами и инфицированием новорожденных. Однако большинство этих исследований было признано плохим. Бактериурия во время беременности также увеличивает риск преэклампсии.
Симптоматическая
Симптоматическая бактериурия - это бактериурия с сопутствующими симптомами инфекции мочевыводящих путей (например, частое мочеиспускание, болезненное мочеиспускание, лихорадка, боль в спине) и включает пиелонефрит или цистит. Наиболее частой причиной инфекций мочевыводящих путей является Escherichia coli.
Диагноз
Тесты на бактериурию обычно проводят у людей с симптомами инфекции мочевыводящих путей. Определенные группы населения, которые не способны ощущать или выражать симптомы инфекции, также проверяются при проявлении неспецифических симптомов. Например, спутанность сознания или другие изменения в поведении могут быть признаком инфекции у пожилых людей. Скрининг на бессимптомную бактериурию во время беременности является обычным делом во многих странах, но вызывает споры.
- для обнаружения бактериурии является бактериальная культура, которая определяет концентрацию бактериальных клеток в моче. Посев обычно комбинируют с последующим MALDI-TOF, который позволяет идентифицировать причинные виды бактерий, и тестом на чувствительность к антибиотикам. Посев мочи является количественным и очень надежным, но для получения результата требуется не менее одного дня. Поэтому клиницисты часто будут лечить симптоматическую бактериурию на основании результатов анализа мочи с помощью индикаторной полоски, ожидая результатов посева.
- Бактериурию обычно можно обнаружить с помощью индикаторной полоски для определения мочи контрольная работа. Тест нитрита обнаруживает нитратредуцирующие бактерии, если они в большом количестве растут в моче. Отрицательный результат теста не исключает бактериурию, так как не все бактерии, которые могут колонизировать мочевыводящие пути, снижают содержание нитратов. Тест лейкоцитарной эстеразы косвенно определяет присутствие лейкоцитов (лейкоцитов ) в моче, которые могут быть связаны с инфекцией мочевыводящих путей. У пожилых людей тест на лейкоцитарную эстеразу часто бывает положительным даже при отсутствии инфекции. Тест-полоска мочи легко доступна и дает быстрые, но зачастую ненадежные результаты.
- Микроскопия также может использоваться для выявления бактериурии. Он редко используется в повседневной клинической практике, так как требует больше времени и оборудования и не позволяет надежно идентифицировать или количественно определить виды бактерий, вызывающих заболевание.
Бактериурия предполагается, если один вид бактерий изолирован в концентрации более 100000 колониеобразующих единиц на миллилитр мочи в образцах мочи, взятых из промежуточного потока. В образцах мочи, взятых у женщин, существует риск бактериального заражения вагинальной флорой. Поэтому в исследованиях обычно анализируется второй образец для подтверждения бессимптомной бактериурии у женщин. Для мочи, собранной с помощью катетеризации мочевого пузыря у мужчин и женщин, диагностическим считается один образец мочи с более чем 100 000 колониеобразующих единиц одного вида на миллилитр. Порог для женщин с симптомами ИМП может составлять всего 100 колониеобразующих единиц одного вида на миллилитр. Тем не менее, бактерии ниже порогового значения в 10000 колониеобразующих единиц на миллилитр обычно сообщаются клиническими лабораториями как «отсутствие роста».
С помощью специальных методов были обнаружены также не вызывающие болезни бактерии в моче здоровых людей. Они являются частью резидентной микробиоты.
Скрининга
Несмотря на споры, многие страны, включая США, рекомендуют однократный скрининг на бактериурию в середине беременности. Метод скрининга: посев мочи.
Лечение
рекомендует проводить скрининг небеременных взрослых против бактериурии. Решение лечить бактериурию зависит от наличия сопутствующие симптомы и сопутствующие заболевания.
Бессимптомная
Бессимптомная бактериурия обычно не требует лечения. Исключение составляют пациенты, перенесшие операцию на мочевыводящих путях, дети с пузырно-мочеточниковым рефлюксом или другие со структурными аномалиями мочевыводящих путей. Во многих странах региональные руководящие принципы рекомендуют лечение беременных женщин.
Нет показаний для лечения бессимптомной бактериурии у диабетиков, реципиентов почечных трансплантатов и у пациентов с травмами спинного мозга.
Чрезмерное использование Антибиотики для лечения бессимптомной бактериурии имеют множество побочных эффектов, таких как повышенный риск диареи, распространение устойчивости к противомикробным препаратам и инфекции, вызванной Clostridium difficile.
Симптоматическая
Симптоматическая бактериурия является синонимом инфекции мочевыводящих путей и обычно лечится антибиотиками. Обычно выбирают нитрофурантоин и триметоприм / сульфаметоксазол.
Бактериурия
Бактериурия – это лабораторный симптом, характеризующий присутствием бактерий в моче. Чаще всего это свидетельствует об инфекции мочевыводящих путей (почек, мочевого пузыря), однако может являться безобидной лабораторной находкой. Клинические проявления могут быть разнообразными – от абсолютно бессимптомного течения до ярко выраженных признаков (повышения температуры тела, боли в пояснице, расстройства мочеиспускания). Наличие бактериальной флоры в моче исследуется несколькими способами – физико-химическими, бактериологическими и т.д. Коррекция бактериурии осуществляется назначением антибактериальных препаратов.
Классификация
В зависимости от количества бактерий некоторые специалисты условно выделяют незначительную и выраженную бактериурию. В клинической практике используется только одна классификация, позволяющая определить тактику лечения пациента:
- Бессимптомная бактериурия. Характеризуется обнаружением в моче бактерий при отсутствии у пациента каких-либо жалоб и других лабораторных признаков инфекций мочевыводящей системы (лейкоцитурии и пр.).
- Симптоматическая бактериурия. Сочетание клинических симптомов и выявления бактерий в образце мочи.
Причины бактериурии
Нарушение подготовки к анализу
Довольно распространенная причина бактериурии. Неправильная подготовка к сдаче анализа мочи, особенно невыполнение или нетщательный туалет наружных половых органов может привести к ложноположительным результатам. Также неправильной считается сдача анализа мочи в период менструации. Кровь, являясь питательной средой для бактерий, создает благоприятную среду для их размножения.
При использовании нестерильной посуды для сбора мочи возможна контаминация пробы посторонней флорой. Для сдачи мочи в бактериологическую лабораторию на посев рекомендуется применять специальные пробирки с консервантами (борной кислотой, формиатом и боратом натрия), стабилизирующими бактериальный состав мочи.
Бессимптомная бактериурия
Обнаружение в моче бактериальной флоры без клинико-лабораторных признаков инфекционно-воспалительных заболеваний МВП встречается у 1-5% здоровых женщин пременопаузального возраста, у 2-10% беременных, у 4-20% здоровых пожилых мужчин и женщин. У молодых здоровых мужчин бессимптомная бактериурия практически никогда не наблюдается.
Такие возрастно-половые особенности бактериурии связаны с анатомо-физиологическими особенностями женской урогенитальной системы, изменениями гормонального фона в период беременности и наступления менопаузы, а также с возрастными изменениями местного иммунитета. Бессимптомная бактериурия является доброкачественным состоянием и не требует никакого вмешательства, за исключением некоторых пациентов, входящих в группу высокого риска по развитию инфекции МВП.
![Бактериурия]()
Инфекции мочевых путей
Наиболее частая причина бактериурии – острые, хронические и рецидивирующие формы инфекций МВП. Возбудителями данных патологий выступают преимущественно грамотрицательные энтеробактерии – кишечная палочка, клебсиелла, протеи. Очень редко инфекции мочеполовой системы вызываются грамположительной флорой – стафилококками, энтерококками. Инфицирование происходит несколькими путями. Самым распространенным признан восходящий путь – через мочеиспускательный канал в мочевой пузырь и/или почки.
Реже возможен гематогенный или лимфогенный путь. Данный вариант возникает при наличии в организме дополнительного очага инфекции – пневмония, инфекции ротовой полости, ЛОР-органов. Степень бактериурии может быть различной, она не коррелирует с тяжестью заболевания и исчезает практически с первых дней лечения при правильно подобранных антибактериальных препаратах.
- Пиелонефрит. Это инфекционное воспаление чашечно-лоханочной системы почек с вовлечением интерстициальной ткани. Развивается преимущественно у молодых женщин (в 5-6 раз чаще, чем у мужчин).
- Цистит. Воспаление слизистой оболочки мочевого пузыря. Однократный эпизод цистита возникает у половины женщин во всем мире.
- Неспецифический уретрит. Воспаление мочеиспускательного канала, напротив, более характерно для мужчин вследствие более длинной и узкой уретры.
Инфекции половых органов
Бактериурия при инфекциях мужских и женских половых органов встречаются очень редко. Они вызываются неспецифической условно-патогенной грамотрицательной и грамположительной флорой (кишечной палочкой, энтерококками, анаэробными бактериями) и часто протекают совместно с циститом, уретритом. Выраженность бактериурии никак не связана с интенсивностью воспалительного процесса.
- Инфекции мужской половой сферы. К ним относятся бактериальный простатит (занимает около 10% от всех случаев воспаления предстательной железы), и крайне редко, орхит и эпидидимит (воспаления яичка и его придатка), баланопостит (воспаление головки и крайней плоти полового члена).
- Инфекции женской половой сферы. Данные инфекции включают воспаления влагалища и/или вульвы (вагинит, вульвовагинит), шейки матки (цервицит).
Стоит отметить, что в случае инфекционных заболеваний половых органов, вызванных бактериями, провоцирующими венерические болезни, такие как хламидиоз, микоплазмоз, гонорея, бактериурия не развивается. Данные инфекции диагностируются другими специальными методами исследования.
Факторы риска бактериурии
К данной группе относятся заболевания или состояния, способствующие появлению в моче микроорганизмов:
- Глюкозурия: плохо контролируемая гипергликемия при сахарном диабете, длительный прием глюкокортикостероидов, различные эндокринные расстройства (болезнь/синдром Иценко-Кушинга, феохромоцитома, глюкагонома).
- Ранее перенесенные ИМП.
- Нарушение оттока мочи: мочекаменная болезнь, врожденные аномалии строения мочевыделительной системы, стеноз мочеточников.
- Обратный заброс мочи: мочепузырно-мочеточниково-лоханочный рефлюкс.
- Наличие установленного мочевого катетера.
- Смещение pH мочи в щелочную сторону: особенности питания, прием лекарственных препаратов.
Диагностика
Существует несколько диагностических способов для выявления бактериурии. Необходимая правильная подготовка перед сдачей анализа. В конкретной клинической ситуации лечащим врачом выбирается определенное исследование либо комбинация методов:
- Микроскопия. Обнаружение бактерий при непосредственном микроскопическом исследовании осадка отцентрифугированной мочи. Метод имеет крайне низкую диагностическую ценность. При микроскопии могут выявляться признаки неправильной подготовки пациента – обилие разнообразной флоры, большое количество слизи и клеток плоского эпителия.
- Тест на нитриты. В процессе жизнедеятельности бактерии, колонизирующие мочеполовой тракт, превращают нитраты, поступающие с пищей, в нитриты. Мочевые тест-полоски имеют специальную реагентную зону, окрашивающуюся в присутствии нитритов. Тест может быть ложноотрицательным при отсутствии в рационе пациента нитратов, инфицировании бактериями, не образующими нитритов (стрептококки), высоком содержании в моче аскорбиновой кислоты.
- Бактериологический посев. Данный способ считается золотым стандартом диагностики бактериурии. В лаборатории выполняется посев образца мочи на питательные среды для определенных бактерий. Для подтверждения диагноза «бессимптомная бактериурия» необходим как минимум 2-кратный посев с промежутком 24 часа. Недостатком метода является длительное время ожидания результата – 2 или 3 дня.
- Проточная цитофлуометрия. Некоторые современные автоматические анализаторы способны проводить подробную оценку клеточного состава пробы мочи, в том числе они подсчитывают количество бактерий.
Микроскопия, нитритный тест и проточная цитометрия считаются ориентировочными методами выявления бактериурии, а микробиологический посев и – подтверждающим. Важный момент – в случае получения роста бактерий, достигающих клинически значимого титра (выше 10х5 колониеобразующих единиц на мл) при посеве, обязательно определяется чувствительность к антибактериальным препаратам. Это необходимо для подбора терапии.
Помимо обнаружения бактериурии, для дифференцирования этиологии ее возникновения, требуются дополнительные исследования:
- Анализ мочи. Показатели ОАМ помогают выяснить причину бактериурии. Например, наличие лейкоцитов и щелочная реакция мочи с высокой вероятностью исключает бессимптомную бактериурию; увеличение содержания белка, эритроцитов может указывать на пиелонефрит. Обнаружение при микроскопии клеток переходного эпителия свидетельствует о поражении мочевого пузыря или уретры, а почечного эпителия и большого числа цилиндров – о поражении почек.
- УЗИ. На УЗИ почек при пиелонефрите отмечается расширение ЧЛС, также можно выявить аномалии строения мочеточников. При простатите на УЗИ предстательной железы выявляется увеличение ее размеров, снижение эхогенности. При эпидидимите на УЗИ яичка визуализируется увеличение придатка, диффузные изменения.
- Осмотр гинеколога. При подозрении на гинекологическое заболевание нужна консультация гинеколога, который проводит осмотр половых органов, бимануальное влагалищное исследование, кольпоскопию. При необходимости выполняется забор мазка со слизистых или отделяемого для культурального исследования.
- Осмотр уролога. Аналогичным образом при наличии показаний мужчинам назначается консультация уролога для пальцевого ректального исследования, забора простатической жидкости или эякулята.
![Бакпосев мочи на питательные среды]()
Коррекция
При обнаружении бактериурии требуется обращение к врачу для проведения коррекции. Бессимтомная бактериурия в подавляющем большинстве случаев не требует лечения. Исключение составляют беременные женщины, пациенты с установленными мочевыми катетерами, больные с плохо контролируемым сахарным диабетом – данным больным показана антибактериальная терапия. При симптоматической бактериурии рекомендуется следующее лечение:
- Пиелонефрит. Препаратами первой линии выступают пециниллины (амоксициллин/квавуланат), цефалоспорины (цефиксим, цефтибутен). При резистентных к ним штаммах прибегают к фторхинолонам (левофлоксацин, ципрофлоксацин), цефалоспоринам нового поколения (цефепим).
- Цистит. Применяются фосфомицина трометамол либо нитрофураны (нитрофурантоин, фуразолидон). При рецидивирующем цистите назначаются препараты на основе экстракта клюквы, D-манноза, растительные средства (канефрон). Также при рецидивах некоторые специалисты рекомендуют лиофилизат бактериального лизата кишечной палочки.
- Инфекции половых путей. При простатите, эпидидимите используются фторхинолоны, макролиды (азитромицин), при вульвовагинитах, цервицитах – инстилляции растворами антисептиков и антибиотики, активные против анаэробной флоры (метронидазол, клиндамицин).
Прогноз
Бактериурия сама по себе не может служить предиктором клинического исхода. Прогноз напрямую определяется основным заболеванием – наиболее благоприятный при бессимптомной бактериурии, циститах, уретритах. Часто возникающий пиелонефрит способствует формированию конкрементов в почках. При тяжелом двустороннем пиелонефрите могут развиться серьезные жизнеугрожающие осложнения – карбункул, абсцесс почки, гидронефроз. Крайне редким и наиболее фатальным последствием пиелонефрита является уросепсис.
1. Бактериурия у беременных с хронической болезнью почек и осложнения в перинатальном периоде/ Нuкольская И.Г., Буёыкuна Т.С., Бочарова И,И., Новuкова С.В., Ефанов А.А., Шuрман Л.И., Крупская М.С. // Росийский вестник акушера-гинеколога. - 2014. - T. 1.
2. Практuческое руководство по антимикробной химиотерапии/ под ред. Л.С. Страчунского, Ю.Б. Белоусова, С.Н. Козлова. - 2007.
Инфекции мочевыводящих путей
Рассказывает ведущий уролог-андролог, внештатный специалист департамента здравоохранения администрации Владимирской области Андрей Александрович Пахалуев.
Тема нашей сегодняшней беседы — инфекции мочевыводящих путей. Такое обозначение мы, врачи-урологи, используем, когда по результатам анализов мы видим наличие бактериальной флоры, но нет явных признаков поражения почек. Иногда в данном случае используется термин «бактериурия». Такой синдром характеризуется наличием бактерий в моче-половых путях, а значит и о активном их размножении. В качестве примера можно рассмотреть пример боли в области мочевого пузыря — цисталгии. Она может быть как однократной, так и повтоярющейся. Такой симптом характерен для неосложнённого цистита.
Давайте сразу уточним, потому что многие люди не очень хорошо знают, где находится мочевой пузырь и где его проекция.
Симптомы инфекции мочевого пузыря — это боли в нижней части живота и дискомфорт при мочеиспускании. Также при цистите могут быть неотложные, сильно выраженные позывы к мочеиспусканию. Такие позывы мы называем императивными.
Также для цистита характерна болезненность при мочеиспускании или после него. Отмечу, что неотложным позывом к мочеиспусканию считается такой, что, когда человек занимался своими привычными делами, ему резко и очень сильно захотелось в туалет. И вот дальше никак, не потерпеть, не переждать, сил терпеть нет.
В классификации заболеваний мочевыводящих путей в отдельную группу выделяют неосложнённые инфекции: к примеру, неосложнённый цистит или пиелонефрит.
К осложнённым заболеваниям относятся циститы, уретриты, пиелонефриты у пациентов с аномалиями или патологиями мочевыводящих путей: с врожденными сужениями (стриктурами), сопутствующими заболеваниями почек, иммунодефицитными заболеваниями. Отдельно можно выделить осложнения на фоне сахарного диабета.
Рецидивирующими инфекциями называют такие, когда воспаление проявляется не более 3 раз в год или не более 2 раз за 6 месяцев. О хронической форме тут говорить рано, но заболевание уже считается рецидивирующим.
В отдельную группу можно выделить катетер-ассоциированные инфекции. Такие заболевания наблюдаются у пациентов, у которых катетер мочевыводящих путей установлен сейчас или был извлечён не позднее 2 дней.
Среди инфекций мочевыводящих путей выделяют уросепсис. Это такой ответ организма на инфекционное заболевание, которое сопровождается системными реакциями: воспалением, высоким лейкоцитозом, дисфункцией органов, гипотонией и множеством других симптомов.
Давайте рассмотрим бессимптомную бактериурию у взрослых. Выявить такие инфекции можно в ходе профосмотра. Первое, что отмечает специалист в общем анализе мочи, — это наличие бактерий. Человека это никак не беспокоило, инфекция была выявлена только в ходе исследования. При выявлении бактерий в анализе мочи можно сделать бактериологический посев и определить вид бактерий.
Микроскопический анализ мочи на бактерии делается всегда. Это очень простое исследование. Выполняется окраска препарата мочи, бактерии будут видны в обычном световом микроскопе.
Бессимптомную бактериурию выявляют у 5% всех женщин. У мужчин этот показатель может достигать 19%.
То, что инфекции мочевыводящих путей — в основном женская болезнь, миф. Мочевыводящая система есть и у мужчин, и у женщин. Болеть могут все.
Если у женщин чаще подвержены воспалению мочевой пузырь и почки, то у мужчин нередко наблюдается воспаление простаты. Микробы этот орган «любят».
Стоит отметить и особенность диагностики. Бактериурия подтверждается при однократном положительном анализе мочи у мужчин. Женщинам рекомендуют сдать такой анализ дважды. Это связано с особенностью сбора мочи и анатомическими особенностями. Подтверждающее исследование назначают, чтобы исключить случайное попадание бактерий с кожи. В двух анализах должен быть выявлен клинически значимый титр бактерий. Это 10 5 колониеобразующих единиц на миллилитр.
Есть несколько особенностей диагностики. При сборе мочи может выполняться исследование количества остаточной мочи в мочевом пузыре. При выявлении уреазопродуцирующих бактерий (например, протеев) необходимо исключить появление камней в почках и мочевыводящих путях. Стоит отметить, что камень может быть дополнительным резервуаром для инфекции.
Для диагностики количества остаточной мочи назначают ультразвуковое исследование. Это достаточно простой и неинвазивный метод, который даёт достаточно точные результаты. Есть ещё метод определения с помощью катетера, но мы его стараемся не применять, так как он инвазивный и требует специальной подготовки.
Для УЗИ пациент приходит с наполненным мочевым пузырём (предварительно выпив большое количество воды). Специалист определяет объём мочевого пузыря, выполняет исследование толщины его стенки. Это исследование может указать на наличие воспаления в стенке мочевого пузыря. После этого пациент идёт в туалет, а затем возвращается для повторного УЗИ. В этот момент определяется количество остаточной мочи.
У мужчин при диагностике после повторного УЗИ проводится пальцевое ректальное исследование предстательной железы. Чато бывает так, что пациент ни на что не жалуется, но при исследовании простаты, нажатии на её доли или срединную бороздку пациент начинает жаловаться на боль.
В норме при исследовании простаты боли быть не должно. Если пациент жалуется на боль или сильный дискомфорт, то можно заподозрить простатит.
Важно отметить, что некоторые пациенты полагают, что их избыточно обследуют. Они периодически оставляют об этом отзывы. Тем не менее, неважных исследований у нас не бывает. До выполнения исследования мы не можем предсказать, даст оно положительный результат или мы исключим какую-либо патологию.
Периодически мы назначаем нашим пациентам и урофлоуметрию — исследование, которое позволяет оценить функцию мочевого пузыря.
Тем не менее, мы никогда не назначаем исследование, потому что сейчас акция.
Иногда можно наблюдать такую картину от пациентов, которые пришли из других клиник. Вместо рутинного исследования — баканализа мочи, выполнена ПЦР. Тем не менее, бактериологическое исследование показывает ещё и чувствительность микроорганизмов к антибактериальным препаратам. Эта информация нам крайне важна. Назначать эмпирическую антибактериальную терапию сейчас достаточно сложно. Многие привычные для нас микроорганизмы стали антибиотикорезистентными. Если раньше согласно национальному руководству всем пациентам с инфекциями мочевыводящих путей назначались фторхинолоны, то сейчас большинство микроорганизмов к ним нечувствительны.
Давайте отдельно разберём цистит. Это достаточно распространённое заболевание. Примерно половина женщин когда-либо сталкивались с этим заболеванием. К факторам риска относится не только половой контакт, спермициды, но и образ жизни, ношение обтягивающего белья, нарушения гигиенических правил, наличие хронических заболеваний.
В большинстве случаев возбудителем выступает кишечная палочка, золотистый стафилококк, клебсиелла, проеи, энтеробактерии. Цистит может вызвать в некоторых случаях klebsiella pneumoniae, которая часто вызывает заболевания в различных органах у людей с иммунодефицитом.
Предварительный диагноз «Цистит» может быть уже поставлен на этапе сбора анамнеза. Это императивные позывы к мочеиспусканию, дизурия. Мы у пациенток уточняем, есть ли выделения из влагалища, чтобы исключить гинекологическую патологию.
Важно отметить, что общий анализ мочи с микроскопией осадка не является заменой бактериологического исследования. В некоторых случаях бак-анализ можно не проводить. Но если была назначена эмпирическая терапия (антибиотик согласно национальному руководству), но симптомы возвращаются в течение 2 — 4 недель, то требуется сделать полноценное исследование. Посев делается при беременности, посев обязательно делается при наличии инфекции мочевыводящих путей у мужчин.
Лучшая антибактериальная терапия — это терапия с учётом чувствительности к антибиотикам, выявленная при бактериологическом посеве. Антибиотикотерапия применяется в течение 5 — 7 дней, затем выполняется контрольное исследование мочи с микроскопией остатка.
Важно отметить, что многие разрекламированные антибиотики в настоящее время являются малоэффективными, просто потому что уже появились штаммы, которые адаптировались к их действию. Даже препаратами выбора уже являются не фторхинолоны, а нитрофураны. Важно: никогда не назначайте себе антибиотик самостоятельно. Это может привести к развитию антибиотикорезистентной инфекции, победить которую будет сложно даже после бактериологического исследования и подбора антибактериальной терапии с помощью теста на чувствительность бактерий к антибиотикам. При правильно подобранном курсе антибиотикотерапии неосложнённого цистита достаточно одного курса антибиотикотерапии, чтобы не только избавиться от симптомов, но и победить болезнь полностью. Если есть осложнения и рецидивы, то приходится выполнять более подробное исследование.
В нашей клинике можно пройти практически весь комплекс диагностических и лечебных процедур. Бак-анализ и анализ на антибиотикорезистентность делается в лаборатории наших партнёров, микроскопию осадка мочи делают в нашей клинике. Также у нас можно выполнить УЗИ мочевого пузыря, простаты, урофлоуметрию.
Перейдите в раздел «Урология«, чтобы узнать больше об оказываемых услугах и специалистах.
Читайте также: